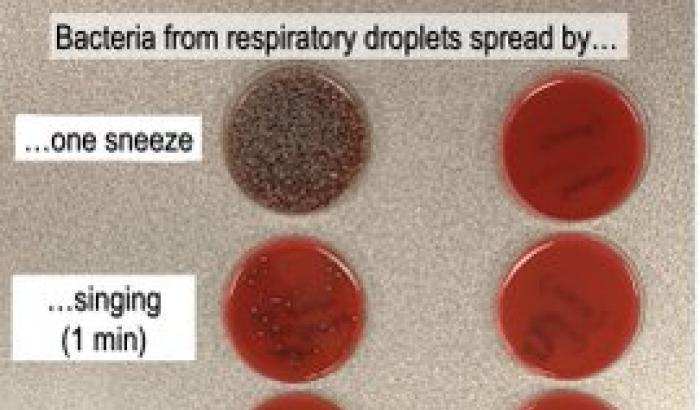

La libertà è il bene più prezioso che si può anche perdere e non è mai facile conquistare. Dovremmo ricordarlo sempre e a questo dovrebbe contribuire la celebrazione del 25 aprile. Per colpa di tutti, non solo della politica ma anche della scuola, degli intellettuali e dei media, e non poco delle famiglie il 25 aprile rischia di diventare solo un giorno di vacanza : non si va in ufficio, non ci sono lezioni, si fa una scampagnata.
Il passare degli anni accentua tutto questo anche se fortunatamente vivono uomini e donne che hanno attraversato quegli anni e hanno partecipato alla Resistenza e alla lotta partigiana. Alla liberazione dell’Italia un contributo determinante fu dato dall’intervento degli Stati Uniti. Ma vi parteciparono progressivamente in modo sempre più qualificato ed efficace formazioni italiane composte anche da giovani che volevano liberarsi dall’occupazione nazista e dalla dittatura di Mussolini. In montagna e nelle valli della nostra penisola, nelle città e nei paesi, con la presenza di militari che avevano disertato, si costituirono formazioni partigiane che -con equipaggiamenti approssimativi e forze modeste, con perdite di compagni ed enormi sacrifici – si sono battute per conquistare la libertà.
Ci sono stati anche episodi feroci da condannare ma in certa misura inevitabili per gli aspetti di guerra civile che la lotta partigiana ha vissuto in certe zone del paese. Ma se pensiamo al voto alle donne, al referendum per la Repubblica, cogliamo i passaggi più decisivi della nuova Italia che scaturiva dalla lotta di liberazione.
Il suo frutto più maturo è stato naturalmente la Costituzione che guida ancora i nostri passi fondamentali. Cio’ non significa ovviamente imbalsamarne il testo e la lettera che vanno anzi adeguati e rinnovati per uno sviluppo della democrazia nella salvaguardia dei principi fondanti e dei valori universali riconosciuti e sanciti dalla nostra Costituzione. Principi e valori che saranno presto sottoposti al nostro giudizio con il prossimo referendum costituzionale di ottobre. Anche per questo fare memoria del 25 aprile non e’solo celebrare una grande vittoria della libertà contro la dittatura . Quella vittoria decisiva di tanti anni fa può aiutarci a capire che la democrazia non è mai compiuta una volta per tutte, che va alimentata ed arricchita continuamente anche per lottare le ingiustizie e la corruzione. Sono i nostri maggiori problemi anche dell’oggi, intossicano la vita sociale e la politica, tolgono speranza e futuro specie ai giovani. Ai tanti radunati a San Pietro papa Francesco ha detto :”non accontentatevi della mediocrità”.Può valere sul terreno civile per celebrare il 25 aprile nel modo migliore. Non basta ricordare l’anniversario e rinnovare gratitudine agli uomini che seppero battersi per la libertà di tutti. Conta non smarrire mai la fiducia nella libertà e nella democrazia, beni irrinunciabili e preziosi da praticare e rinnovare giorno per giorno.